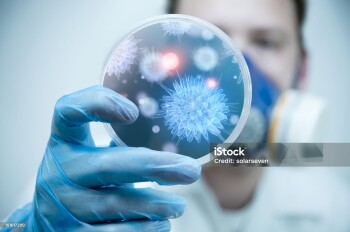
A scientist holding a Petri Dish with Virus and bacteria cells.

Тег: ОРВИ
20.02.2026, 12:45
В Казахстане заболеваемость ОРВИ и гриппом снизилась на 13%22.01.2026, 12:15
Эпидситуация по гриппу и ОРВИ в ЗКО характеризуется как благополучная13.11.2025, 15:30
О текущей ситуации по ОРВИ и гриппу в мире рассказали медики13.11.2025, 15:15
Около 2 млн казахстанцев получили вакцину против гриппа5.11.2025, 11:00
Минздрав: эпидситуация по ОРВИ и гриппу остается под контролем21.10.2025, 17:25
Минздрав дает рекомендации по профилактике сезонного ОРВИ и гриппа28.03.2025, 10:30
В ЗКО эпидсезон обошелся без карантина17.03.2025, 18:00
Эпидситуация в РК остается стабильной по всем основным видам инфекции20.01.2025, 16:00
Минздрав дал рекомендации по медпомощи беременным с тяжелой формой ОРВИ13.12.2024, 11:45
Эпидсезон требует подстраховки12.12.2024, 15:30
В Казахстане эпидемиологическая ситуация по ОРВИ и гриппу стабильная21.11.2024, 15:02
В ЗКО болеть ОРВИ стали реже27.10.2024, 15:00
Врач назвала простые способы избавиться от боли в горле без лекарств27.09.2024, 17:01
На кону – людские жизни10.01.2024, 11:45
Часто болеешь, школьник? Нужна реабилитация!28.12.2023, 18:00
Праздник праздником, а про вирусы лучше не забывать!28.11.2023, 18:00
Панику казахстанцев из-за новой пандемии прокомментировали в Минздраве7.08.2023, 18:00
Летние болезни: можно ли подхватить ангину от мороженого